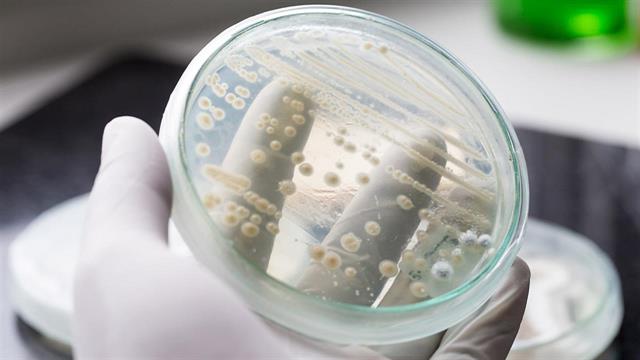
Το ανοσοποιητικό σύστημα βοηθά μύκητα να εξαπλωθεί στο σώμα

Ειδικά το ανοσοποιητικό σύστημα βοηθά έναν ζυμομύκητα να εξαπλωθεί στο σώμα. Αυτό το νέο εύρημα ερευνητών του Πανεπιστημίου της Βέρνης βοηθά στην αναζήτηση νέων θεραπειών κατά της δηλητηρίασης του αίματος που προκαλείται από ζυμομύκυτες. Αυτές εξακολουθούν να αντιμετωπίζονται δύσκολα και συνδέονται με υψηλό ποσοστό θνησιμότητας, ανακοίνωσε το Πανεπιστήμιο της Βέρνης. Το ένα τρίτο έως το ήμισυ των ασθενών δεν επιβιώνουν από μια τέτοια μυκητιασική σήψη.
Σύμφωνα με τους ερευνητές, ο ζυμομύκητας Candida albicans αποικίζει περίπου τον μισό πληθυσμό. Ωστόσο, γίνεται πρόβλημα μόνο όταν εισέρχεται στην κυκλοφορία του αίματος και προκαλεί δηλητηρίαση του αίματος. Αυτό μπορεί να συμβεί, για παράδειγμα, αν μια ασθένεια όπως το AIDS αποδυναμώνει το ανοσοποιητικό σύστημα ή αν μια χειρουργική επέμβαση βλάψει τον φραγμό των βλεννογόνων.
Όταν εισβάλλουν παθογόνα, το ανοσοποιητικό σύστημα αντιδρά με φλεγμονή, όπως εξηγεί το Πανεπιστήμιο. Μια πρωτεΐνη που ονομάζεται ανταγωνιστής του υποδοχέα της ιντερλευκίνης 1 βοηθά στον έλεγχο της φλεγμονής.
Ωστόσο, όπως κατάφεραν τώρα να δείξουν οι ερευνητές σε μελέτη που δημοσιεύθηκε στο περιοδικό "Immunity", η πρωτεΐνη αυτή προωθεί επίσης την εξάπλωση του μύκητα.
Ποντίκια που είχαν εκτραφεί γενετικά με τέτοιο τρόπο ώστε τα φαγοκύτταρά τους να μην παράγουν καμία από τις αντιφλεγμονώδεις πρωτεΐνες ήταν σε θέση να καταπολεμήσουν με επιτυχία μια μόλυνση με Candida albicans μέσα σε σύντομο χρονικό διάστημα.
Συγκεκριμένα, η πρωτεΐνη ανταγωνιστής του υποδοχέα της ιντερλευκίνης 1 διαταράσσει την άμυνα του ανοσοποιητικού συστήματος αναστέλλοντας την παραγωγή και την κίνηση ορισμένων λευκών αιμοσφαιρίων που ονομάζονται ουδετερόφιλα, ανέφεραν οι ερευνητές.
Αυτά τα ουδετερόφιλα είναι σημαντικά επειδή καταπολεμούν τους παθογόνους μικροοργανισμούς, είπαν. Επειδή η πρωτεΐνη αναστέλλει τα ουδετερόφιλα, οι μύκητες μπορούν να εξαπλωθούν.
Ειδήσεις υγείας σήμερα
Χρόνια νεφρική νόσος: Τι πρέπει να γνωρίζουμε
Πώς θα προλάβουμε τον διαβήτη
Αλκοόλ και αντικαταθλιπτικά: Γιατί δεν πρέπει να τα συνδυάζουμε
Ποιο αντιμυκητιασικό φάρμακο προκαλεί παρενέργειες και πότε
Ποιο αντιμυκητιασικό φάρμακο προκαλεί παρενέργειες και πότε Ερευνήτρια προειδοποιεί για αυξανόμενη απειλή από ανθεκτικούς μύκητες
Ερευνήτρια προειδοποιεί για αυξανόμενη απειλή από ανθεκτικούς μύκητες Candida auris: Όσα πρέπει να γνωρίζετε για τον ανθεκτικό μύκητα [ερώτηση - απάντηση]
Candida auris: Όσα πρέπει να γνωρίζετε για τον ανθεκτικό μύκητα [ερώτηση - απάντηση] Candida auris: Σιωπηλή κρίση ''υπερμύκητα'' στην Ελλάδα;
Candida auris: Σιωπηλή κρίση ''υπερμύκητα'' στην Ελλάδα; Ορισμένα μικρόβια και μύκητες στο στόμα συνδέονται με αυξημένο κίνδυνο καρκίνου στο πάγκρεας [Μελέτη]
Ορισμένα μικρόβια και μύκητες στο στόμα συνδέονται με αυξημένο κίνδυνο καρκίνου στο πάγκρεας [Μελέτη] Ο Γκ. Μαγιορκίνης για τον επικίνδυνο μύκητα στα νοσοκομεία
Ο Γκ. Μαγιορκίνης για τον επικίνδυνο μύκητα στα νοσοκομεία Χρόνια νεφρική νόσος: Τι πρέπει να γνωρίζουμε
Χρόνια νεφρική νόσος: Τι πρέπει να γνωρίζουμε Πώς θα προλάβουμε τον διαβήτη
Πώς θα προλάβουμε τον διαβήτη Αλκοόλ και αντικαταθλιπτικά: Γιατί δεν πρέπει να τα συνδυάζουμε
Αλκοόλ και αντικαταθλιπτικά: Γιατί δεν πρέπει να τα συνδυάζουμε Μικροβιακή αντοχή: Μία πανδημία σε αργή κίνηση που μπορούμε να αποτρέψουμε
Μικροβιακή αντοχή: Μία πανδημία σε αργή κίνηση που μπορούμε να αποτρέψουμε 'Εγκριση της ουσίας μιταπιβάτη στην Ευρωπαϊκή Ένωση για ενήλικες ασθενείς με θαλασσαιμία
'Εγκριση της ουσίας μιταπιβάτη στην Ευρωπαϊκή Ένωση για ενήλικες ασθενείς με θαλασσαιμία Η Ελλάδα πρώτη σε θανάτους από καρκίνο στην ΕΕ και δεύτερη στον ΟΟΣΑ [πίνακας]
Η Ελλάδα πρώτη σε θανάτους από καρκίνο στην ΕΕ και δεύτερη στον ΟΟΣΑ [πίνακας] Προβλήματα πρόσβασης σε θεραπεία αποσιδήρωσης [infographic]
Προβλήματα πρόσβασης σε θεραπεία αποσιδήρωσης [infographic] Τι αλλάζει για νοσηλευτές-διασώστες η ένταξη στα Βαρέα και Ανθυγιεινά
Τι αλλάζει για νοσηλευτές-διασώστες η ένταξη στα Βαρέα και Ανθυγιεινά Αντιμετώπιση της παχυσαρκίας: Mια προτεραιότητα της πολιτικής για τη βιωσιμότητα του συστήματος υγείας
Αντιμετώπιση της παχυσαρκίας: Mια προτεραιότητα της πολιτικής για τη βιωσιμότητα του συστήματος υγείας Κεραμέως: Βαρέα και ανθυγιεινά για νοσηλευτές και διασώστες ΕΚΑΒ
Κεραμέως: Βαρέα και ανθυγιεινά για νοσηλευτές και διασώστες ΕΚΑΒ Άνοιξε η πόρτα για αποζημίωση των CGM σε άτομα με διαβήτη τύπου 2 που λαμβάνουν ινσουλίνη
Άνοιξε η πόρτα για αποζημίωση των CGM σε άτομα με διαβήτη τύπου 2 που λαμβάνουν ινσουλίνη Απώλεια μυϊκής μάζας με τους αγωνιστές GLP-1 ανησυχεί τους ειδικούς
Απώλεια μυϊκής μάζας με τους αγωνιστές GLP-1 ανησυχεί τους ειδικούς